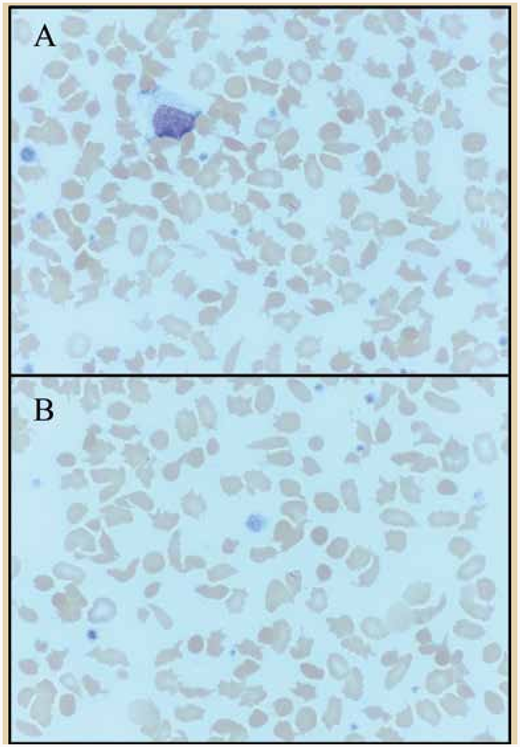
Figure.

A 42-year-old man with metastatic lung adenocarcinoma presented with disease progression on positron emission tomography/computed tomography scan after 15 months of stable disease while on pembrolizumab. Molecular testing revealed an EML4-ALK fusion, and the patient was started on the anaplastic lymphoma kinase (ALK) inhibitor alectinib. Prior to alectinib therapy, his hemoglobin ranged from 12.3 to 13 g/dL. Three months after initiating therapy, his hemoglobin ranged from 11.5 to 12 g/dL (Table). Review of peripheral blood smears while on alectinib therapy revealed marked acanthocytosis with occasional schistocytes, spherocytes, and microcytes (Figure; magnification ×1,000).
| Test . | Result . | Reference Range . |
|---|---|---|
| Hemoglobin | 11.8 g/dL | 13.5-17.7 g/dL |
| Hematocrit | 34.5% | 40-52% |
| Mean cell volume | 73.5 fL | 82-98 fL |
| Mean corpuscular hemoglobin concentration | 34.3 g/dL | 32-36 g/dL |
| Red cell distribution width | 23.5% | 11.5-14.5% |
| Platelet count | 341 × 109/L | 150-400 × 109/L |
| White cell count | 10.1 × 109/L | 4-11 × 109/L |
| Total bilirubin | 1.3 mg/dL | 0.2-1.3/0-0.3 mg/dL |
| Test . | Result . | Reference Range . |
|---|---|---|
| Hemoglobin | 11.8 g/dL | 13.5-17.7 g/dL |
| Hematocrit | 34.5% | 40-52% |
| Mean cell volume | 73.5 fL | 82-98 fL |
| Mean corpuscular hemoglobin concentration | 34.3 g/dL | 32-36 g/dL |
| Red cell distribution width | 23.5% | 11.5-14.5% |
| Platelet count | 341 × 109/L | 150-400 × 109/L |
| White cell count | 10.1 × 109/L | 4-11 × 109/L |
| Total bilirubin | 1.3 mg/dL | 0.2-1.3/0-0.3 mg/dL |
Which of the following is the most likely cause of his anemia and the associated red blood cell changes observed on peripheral blood smear?
Medication side effect
Autoimmune hemolytic anemia
Acquired thalassemia
Anemia of chronic disease
Visit ashpublications.org/thehematologist/pages/image_challenge to take the quiz and get the answer.
Competing Interests
Dr. Yeung, Dr. Fei, and Dr. Fernandez-Pol indicated no relevant conflicts of interest.